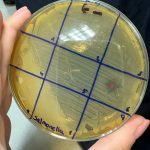
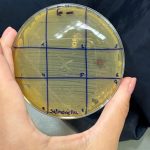
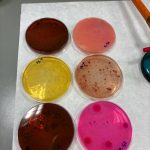
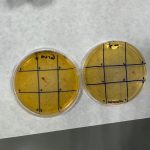

Concluye el último curso de los Training Network Courses que ofertaba el ceiA3 este 2025 en la Universidad de Jaén
La formación ofertada con el apoyo de Santander Universidades, “Antagonismo microbiano y control microbiológico en la cadena alimentaria”, ofrece una visión aplicada sobre el papel de los microorganismos en la seguridad alimentaria.
En noviembre ha concluido en la Universidad de Jaén el curso especializado “Antagonismo microbiano y control microbiológico en la cadena alimentaria”, una propuesta formativa que ha abordado la importancia de los microorganismos y sus productos microbianos en el control de patógenos y alterantes, ofreciendo alternativas sostenibles a los conservantes químicos.
La iniciativa forma parte de la oferta Training Network Courses (TNC) impulsada por el Campus de Excelencia Internacional Agroalimentario ceiA3, del que forma parte la UJA, con el apoyo de Santander Universidades, y está dirigida a estudiantes de Máster y Doctorado que buscan una formación altamente especializada y de calidad en el ámbito de la microbiología aplicada al sector agroalimentario.
El curso, dirigido académicamente por María José Grande Burgos, ha contado con la participación de profesorado adscrito al grupo de investigación “Microbiología de los alimentos y del medio ambiente | AGR-230” de la Universidad de Jaén. Además, ha incluido la colaboración de representantes de empresas y centros tecnológicos del sector, con el objetivo de aportar la perspectiva empresarial y fomentar la empleabilidad del alumnado.
Según ha destacado la dirección del curso, “la participación de personal altamente cualificado procedente de empresas permitirá crear vínculos que sirvan de base para futuras colaboraciones, la realización de Trabajos Fin de Máster y posibles oportunidades laborales”.
El programa, que se ha desarrollado del 3 al 13 de noviembre, comenzó con una conferencia impartida por el Profesor Dr. Antonio Gálvez del Postigo Ruiz, coordinador del área de Microbiología de la UJA, director del Máster Avances en Seguridad de los Alimentos y responsable del grupo de investigación AGR-230. Según ha avanzado el curso, han intervenido también docentes de la Universidad de Jaén como Magdalena Martínez Cañamero, Elena Ortega Morente, Rosario Lucas López y Rubén Pérez Pulido, además del Profesor Antonio Cobo Molinos, de la Universidad de Granada.
Las sesiones prácticas, desarrolladas en los laboratorios docentes, han sido coordinadas por María José Grande Burgos, y han incluido talleres y seminarios impartidos por profesionales de empresas como DOMCA, Family Biscuits y Ctaqua, que aportan una visión aplicada del sector agroalimentario y sus retos tecnológicos. La formación ha durado 35 horas distribuidas en 10 sesiones teóricas (25 horas) y 3 sesiones prácticas (10 horas), combinando así la enseñanza científica con la aplicación industrial.
Los Training Network Courses (TNC) tienen como objetivo ofrecer un aprendizaje avanzado en áreas de vanguardia dentro del marco del ceiA3, fomentando la colaboración interuniversitaria y la conexión entre la investigación académica y los entornos laborales. Además, esta iniciativa busca captar talento y promover sinergias entre universidades, centros de investigación y empresas del sector agroalimentario. El curso se enmarca en el convenio ceiA3–Banco Santander Universidades, financiado por el Gobierno de España y la Junta de Andalucía a través del Programa Campus de Excelencia Internacional.
![]()